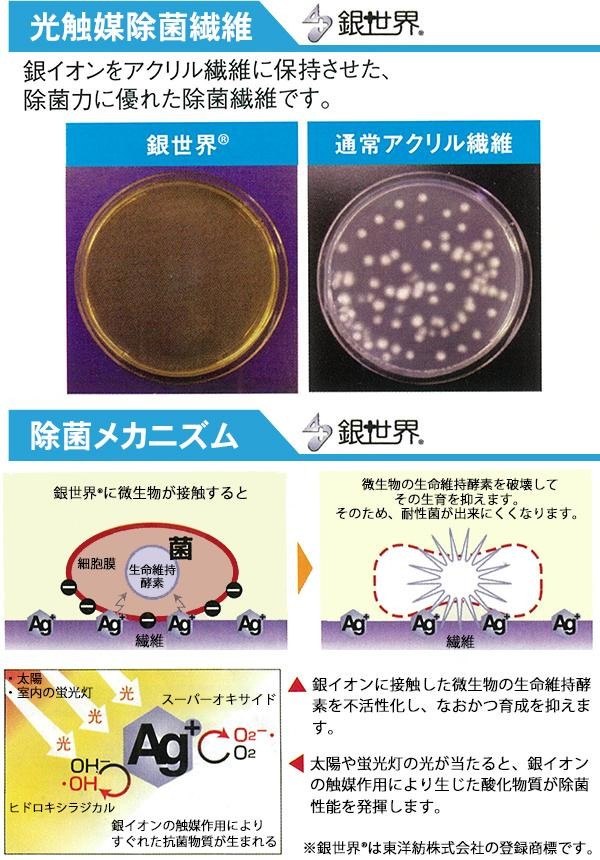

| ペットのいるお部屋の臭い対策におすすめのマット!! |

|
除菌力に優れた除菌繊維である「銀世界(R)」と、ペット臭やトイレなどのアンモニア臭を吸着し消臭する繊維である「ディスメル(R)」を使用したペット用マットです。裏面の特殊加工により、吸収した水分を床に漏らすことがありません。吸収・消臭効果は天日干しや洗濯によって回復、いつでも清潔な状態でお使いいただけます。 |
fk094igrjs
| 除菌力に優れた除菌繊維である「銀世界(R)」と、ペット臭やトイレなどのアンモニア臭を吸着し消臭する繊維である「ディスメル(R)」を使用したペット用マットです。裏面の特殊加工により、吸収した水分を床に漏らすことがありません。吸収・消臭効果は天日干しや洗濯によって回復、いつでも清潔な状態でお使いいただけます。 |
| サイズ | 90×180cm 個装サイズ:46×31×5cm |
| 重量 | 個装重量:760g |
| 素材・材質 | 表面:エステル、銀世界(R)、東洋紡ディスメル(R)・承認No.JP-218H 裏面:ポリウレタン |
| 仕様 | 脱水機使用可、乾燥機使用不可 縁加工 |
| 製造国 | 日本 |